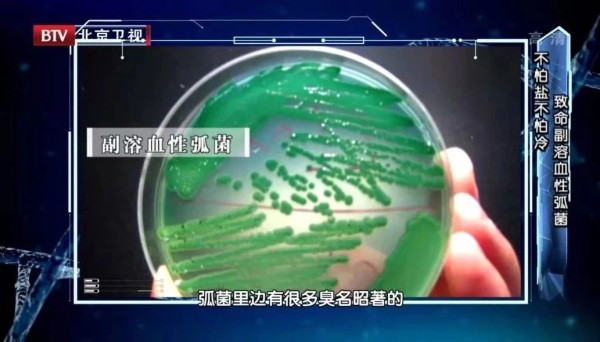

年末打扫有6大“清洁盲区”,可能暗藏“致病菌”,很多家庭都漏了!一旦感染就危险了!
误区:感冒了多喝水就能好,有时反而可能导致脱水。 #生活常识# #常见误区#
过年之前家家户户都要进行一次大扫除,这是我国的传统民俗之一,也寓意着扫尽霉气,招来好运~
不过,真正的清扫可不是简单的清垃圾、抹灰尘那么简单。家中每个不起眼的角落,都可能藏着细菌“大军”,有些细菌甚至像炸弹一样,随时会威胁生命安全!
来看看这些“致命菌”最爱躲在哪?要怎么清理?
1
大肠杆菌:暗藏于马桶和洗衣机
大肠杆菌属于条件致病菌,在我们肠道里时,通常不会引起什么疾病,但等到它们被排泄出来,随着受污染的水到处流窜时,就开始“作妖”了。
一旦人体感染大肠杆菌后,轻则引起腹泻,严重的还可能会导致肠出血,甚至诱发溶血性尿毒综合征。
1
马桶座套,是细菌温床
冬天很多人喜欢在马桶外面套一个座套,以避免直接接触马桶的“凉意”。

而大肠杆菌喜欢马桶座套的温暖,再加上,上面有很多细小的空隙,利于大肠杆菌的存留繁殖,因而很有可能成为大肠杆菌存活的温床。
建议:马桶座套也要频繁更换或清洁。可以把座套放在烧开的水中,浸泡五分钟,就可以消灭大量的大肠杆菌,频率为一周一次为宜。也可以用75%的酒精仔细擦洗,这样就可以去除大量的细菌。
另外,除了大肠杆菌,马桶和马桶套上可能还有10万多个细菌对身体健康虎视眈眈。因而建议大家1-2天用洁厕灵或84消毒液等清洗一次马桶壁。

2
用久了的洗衣机
很多家庭都没有清洁洗衣机的习惯,但你相信吗?用久的洗衣机比马桶还脏——实验室的一项调查显示,三年没洗的洗衣机,内筒中的细菌含量可高达70多万。
你看不到的洗衣机内桶外壁、排污槽,其实都是藏污纳垢的重要场所。再加上湿润的环境,大量病菌滋生。
上海市疾控中心曾抽样检查了128台使用半年以上的洗衣机,结果显示,居民洗衣机的污渍中,总大肠杆菌检出率高达100%,霉菌的检出率为60.2%。
清理小窍门:25g小苏打、100ml白醋,用清水调匀后倒入洗衣机漂洗几次,即可有效清洗洗衣机。
2
霉菌,多见于浴室和厨房
霉菌能致癌、致畸、致过敏,且被世界卫生组织列入一等致癌物,毒性可高达砒霜的68倍。
1
浴室密封胶
霉菌,喜欢高温潮湿的环境,卫生间很容易成为“危险地带”。墙角、瓷砖缝、浴室帘子、水龙头等处,都可能出现霉菌。而这其中浴室密封胶很可能成为“霉菌重度污染处”。

有数据显示,在全球范围内,浴室密封胶是最脏的地方,70%的家庭在细菌检测中达到了重度污染,56%的家庭在霉菌测试中被发现为重度污染。
清理窍门:用一份漂白剂兑上10份水(1:10的比例),餐巾纸在兑好的水里浸湿,贴在长霉菌的地方至少半个小时,揭开后用刷子刷干净即可。
2
冰箱门
冰箱门上的密封条能增强制冷效果,但其乳胶和塑料的密封条会滋生大量霉菌,进而污染冰箱内的食物,导致腹泻、腹痛等。

霉菌繁殖以孢子为基础,孢子的生命力非常顽强,甚至能够抵抗零下50多度的低温!虽然在零下10度就不繁殖,但是没有被杀死,温度上升就恢复生命活力。
看看你家冰箱的密封条是不是已经出现黑色斑点了?得赶紧清洗了!
清除窍门:我们可以用酒精和可乐1:1的比例兑好,吸水性强的纱布或纸缠绕在叉子上,蘸一蘸溶液,沿着冰箱门缝隙清除霉菌。
3
久用的砧板、筷子
每天做饭、切肉、切菜、切水果全都离不开案板,久而久之,案板上就会残留一些脏东西或者油污,若不彻底清洗干净,在潮湿的环境中,案板就会滋生大量细菌。而长毛、发黑、有裂缝的案板中有可能存在霉菌。

砧板使用半年后就要进行更换,若出现刀痕过多、发霉情况更要及时更换。
除了陈年案板,存放不当的木筷、坚果等也容易产生霉菌。普通的竹制或者木制的筷子,一年左右就应该更换了,如果是比较潮湿的环境,建议3个月一换。发霉、有哈喇味的食物则立刻丢掉不再食用。
清洗窍门:将小苏打均匀洒在砧板上,然后喷洒少量水,用刷子刷洗干净,放于通风处晾干。
3
军团菌,偏爱水龙头和加湿器
军团菌也叫“偷肺菌”,最早在美国退伍军人协会中被发现,造成221人感染,34人死亡。其感染人体后,主要侵犯肺脏,不仅会引起重症肺炎,其他脏器也可能受累。如果治疗不当,死亡率可达45%。

1
水龙头、花洒
花洒、水龙头等容易积累水垢,是军团菌喜欢的藏身之处。而花洒喷出的水雾最易传播军团菌。如果洗澡时深吸气或引吭高歌,就容易导致军团菌入侵人体。

清洗步骤:
①往盆中倒入清水,按照1:50的比例倒入双氧水,将卸下的花洒放置其中浸泡20分钟;
②将柠檬切成薄片,大火烧开,浇在花洒上,再浸泡20分钟以上;
③用牙刷或绣花针清洁花洒即可。每3-6个月清洗一次。
2
加湿器
冬季气候干燥,皮肤很容易出现刺痛、脱皮等,很多家庭习惯使用加湿器,但往往都是灌满自来水后一直使用。其实加湿器不及时换水、不注意清洁,就可能滋生军团菌,并通过雾气进行传播,引发肺部感染。
加湿器正确使用法则:
①加湿器中的水最好使用纯净水,避免使用白开水、自来水等。
②清洗时可以用1L水+10ml双氧水混合,制成浓度为1%的双氧水溶液,倒入加湿器,停留1小时后,用刷子刷洗加湿器内部,起到除菌的作用。
③室内的湿度应该控制在40~60%,因而每次使用加湿器的时间最好不要超过2小时。而且加湿器也最好不要放置在床头,以远离床头2米为宜。

4
副溶血性弧菌,主要在海鲜中
副溶血弧菌被称为现代“霍乱”。它多数是通过饮食感染人体,其分泌的溶血毒素、肠毒素等,可导致细胞破坏、黏膜损伤,最终引起多脏器功能衰竭;还可以通过血液感染,引起严重的脓毒血症,甚至导致死亡。
副溶血性弧菌是一种海洋细菌,主要来源于鱼、虾、蟹、贝类和海藻等海产品。因而处理和食用这些海产品时要格外注意。
①处理海鲜的时候最好戴上手套,避免划伤手造成感染。
②对加工海产品的器具必须严格清洗、消毒。盛装生、熟食品的用具要分开,避免厨房交叉感染。
③尽量煮熟吃,避免生食,尤其是现在在新冠疫情下,完全煮熟为好;实在想要生吃的最好在醋中浸泡几分钟。因为副溶血性弧菌怕热也怕酸。

5
沙门氏菌,鸡蛋是主要感染来源
沙门氏菌是引起细菌性食物中毒最常见、比例最大的致病菌,主要危害胃肠道,表现为肚子绞痛、上吐下泻,有时伴随发烧。
1
正确处理鸡蛋
鸡蛋,是沙门氏菌的主要来源,而鸡蛋表皮的细菌数量,与价格以及外表的干净程度没有直接关系。2010年美国加利福利亚州,很多人吃了吃蛋后发生了严重的感染。

那么,如何正确挑选、处理鸡蛋,减少感染风险?
①正规商超购买
如果母鸡肠道内有沙门氏菌,那么生下的鸡蛋就会携带沙门氏菌。一些农村的土鸡蛋没有经过检疫,沙门氏菌污染的风险相对较高。所以,建议大家在正规商超购买合格产品。
②刚买回来的鸡蛋先不要清洗,因为鸡蛋壳的外面有一层包膜,它可以防止细菌侵入到鸡蛋内部。直接将大的一头朝上,放在冰箱靠里面的位置。

③烹饪鸡蛋前,可戴上手套,将鸡蛋放在流水下冲洗20秒以上,去除表面的脏东西。且最好做熟吃。
6
隐球菌,存于阳台植物
案例
一位62岁的女性,经常出现头疼头晕的症状,一直以为是血压不稳,也没太在意。在出现视物模糊、失明情况后,她才意识到病情的严重性,赶紧就医诊治。
经医生分析,她的中枢神经系统受到了隐球菌感染,而这与她种植的盆栽有关。

隐球菌被称为“食脑菌”,主要通过呼吸进入人体,先经过肺部,再进入脑部。由于隐球菌外面存在荚膜,其中的抗原成分能帮助它逃过免疫系统的攻击,从而容易穿过血脑屏障,引起中枢神经系统感染病变。
隐球菌经常出现在植物土壤中,处理含有鸟粪、腐叶等的植物时,要特别注意。

建议:每隔两三个月,用2%~4%的84消毒液对盆栽土壤进行消毒,或将盆栽土壤搬到阳光下晾晒,帮助消除隐球菌。
来源:BTV我是大医生
网址:年末打扫有6大“清洁盲区”,可能暗藏“致病菌”,很多家庭都漏了!一旦感染就危险了! https://www.yuejiaxmz.com/news/view/1388748
相关内容
这三大致病菌!就藏在你卧室的这些角落厨房竟如此危险!从用具到做菜习惯,都可能暗藏杀机!看看你中招了吗?
一个卫生间就有7处藏有“致命毒素”家里这些“想不到”的地方也很危险
冰箱用不对=吃细菌!90%以上的家庭都做错了,严重时可致命
灶台旁边别乱放!这6种东西暗藏危险,很多家庭一直都在犯错!
七旬大爷节前大扫除,没想到感染了肺曲霉病
家庭生活中,大家都必须了解的6个常识!忽略了有危险!
这样做可能很危险,6个常见清洁误区
冰箱用不对=吃细菌!90%以上的家庭都做错了,严重时可致命!
藏在厨房里的潜在危险,家家都有……

